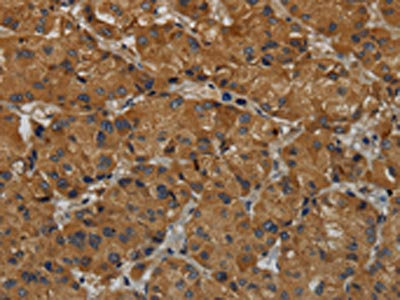

-
中文名稱:MAS1兔多克隆抗體
-
貨號:CSB-PA084695
-
規格:¥1100
-
圖片:
-
The image on the left is immunohistochemistry of paraffin-embedded Human colon cancer tissue using CSB-PA084695(MAS1 Antibody) at dilution 1/50, on the right is treated with fusion protein. (Original magnification: ×200)
-
The image on the left is immunohistochemistry of paraffin-embedded Human liver cancer tissue using CSB-PA084695(MAS1 Antibody) at dilution 1/50, on the right is treated with fusion protein. (Original magnification: ×200)
-
-
其他:
產品詳情
-
Uniprot No.:
-
基因名:
-
別名:MAS1; MAS; Proto-oncogene Mas
-
宿主:Rabbit
-
反應種屬:Human,Mouse,Rat
-
免疫原:Fusion protein of Human MAS1
-
免疫原種屬:Homo sapiens (Human)
-
標記方式:Non-conjugated
-
抗體亞型:IgG
-
純化方式:Antigen affinity purification
-
濃度:It differs from different batches. Please contact us to confirm it.
-
保存緩沖液:-20°C, pH7.4 PBS, 0.05% NaN3, 40% Glycerol
-
產品提供形式:Liquid
-
應用范圍:ELISA,IHC
-
推薦稀釋比:
Application Recommended Dilution ELISA 1:2000-1:5000 IHC 1:50-1:200 -
Protocols:
-
儲存條件:Upon receipt, store at -20°C or -80°C. Avoid repeated freeze.
-
貨期:Basically, we can dispatch the products out in 1-3 working days after receiving your orders. Delivery time maybe differs from different purchasing way or location, please kindly consult your local distributors for specific delivery time.
-
用途:For Research Use Only. Not for use in diagnostic or therapeutic procedures.
相關產品
靶點詳情
-
功能:Receptor for angiotensin 1-7. Acts specifically as a functional antagonist of AGTR1 (angiotensin-2 type 1 receptor), although it up-regulates AGTR1 receptor levels. Positive regulation of AGTR1 levels occurs through activation of the G-proteins GNA11 and GNAQ, and stimulation of the protein kinase C signaling cascade. The antagonist effect on AGTR1 function is probably due to AGTR1 being physically altered by MAS1.
-
基因功能參考文獻:
- These findings suggest a critical role for MasR in cardiomyocyte survival. PMID: 29052864
- ANG-(1-7) acts on the receptor MAS to influence a range of mechanisms in the heart, kidney, brain, and other tissues. [review] PMID: 29351514
- These findings suggest that mitochondrial assembly receptor signaling may be a promising novel target for oral tongue squamous cell carcinoma. PMID: 28747140
- High levels of MAS is associated with angiogenesis in bladder cancer. PMID: 28599664
- Here, we review the role and effects of ACE2, ACE2 activators, Ang-(1-7) and synthetic Mas receptor agonists in the control of inflammation and fibrosis in cardiovascular and renal diseases and as counter-regulators of the ACE-Ang II-AT1 axis. PMID: 26995300
- Downregulation of ACE2/Ang-(1-7)/Mas axis stimulates breast cancer metastasis through the activation of store-operated calcium entry and PAK1/NF-kappaB/Snail1 pathways. PMID: 27063099
- These results indicated that angiotensin-(1-7)/ACE2/Mas axis may reduce liver lipid accumulation partly by regulating lipid-metabolizing genes through ATP/P2 receptor/CaM signaling pathway. PMID: 26883384
- Ang-(1-7) downregulated AT1R mRNA, upregulated mRNA levels of Ang II type 2 receptor (AT2R) and Mas receptor (MasR) and p38-MAPK phosphorylation and suppressed H22 cell-endothelial cell communication PMID: 26225830
- MAS1 might act as an inhibitory regulator of breast cancer. PMID: 26080617
- Data show that MAS receptor exhibited constitutive activity that was inhibited by the non-peptide inverse agonist. PMID: 25068582
- Data suggest that angiotensin converting enzyme 2/angiotensin II-(1-7)/MAS1 axis regulates leukocyte recruitment/activation, cell proliferation, and inflammation/fibrosis; main topic here is kidney/inflammatory renal disease. [REVIEW] PMID: 23488800
- Up-regulation of the ACE2/Ang-(1-7)/Mas axis protected against pulmonary fibrosis by inhibiting the MAPK/NF-kappaB pathway. PMID: 24168260
- A proximal promoter construct for the MAS gene was repressed by the SOX [SRY (sex-determining region on the Y chromosome) box] proteins SRY, SOX2, SOX3 and SOX14, of which SRY is known to interact with the KRAB domain. PMID: 24128372
- Mas appears to be a critical component required for NO-mediated vasodilatation induced by renin angiotensin system-dependent and RAS-independent agonists and therefore arises as a key pharmacological target to modulate endothelial function PMID: 23459756
- Control of adipogenesis by the autocrine interplays between angiotensin 1-7/Mas receptor and angiotensin II/AT1 receptor signaling pathways. PMID: 23592774
- MasR was significantly upregulated in colon adenocarcinoma compared with non-neoplastic colon mucosa, which showed little or no expression of it. ACE gene expression and enzymatic activity were also increased in the tumors. PMID: 22048948
- Activation of Mas during myocardial infarction contributes to ischemia-reperfusion injury and suggest that inhibition of Mas-G(q) signaling may provide a new therapeutic strategy directed at cardioprotection. PMID: 22003054
- Report expression (pro)renin receptors and angiotensin converting enzyme 2/angiotensin-(1-7)/Mas receptor axis in human aortic valve stenosis. PMID: 21316680
- Angiotensin-(1-7), its receptor Mas, and ACE2 are expressed in the human ovary PMID: 20674894
- The immunolocalization of Ang-(1-7) and its receptor Mas in testes of fertile and infertile men suggests that this system may be altered when spermatogenesis is severely impaired. PMID: 20361351
- the ability of MAS to up-regulate AT(1) receptor levels reflects the constitutive capacity of MAS to activate Galpha(q)/Galpha(11) and hence stimulate PKC-dependent phosphorylation of the AT(1) receptor PMID: 16611642
- Mas, MrgD, and MRG mediated Ang IV-stimulated AA release that was highest for Mas. While Ang III activated Mas and MrgX2, Ang II stimulated AA release via Mas and MRG. PMID: 18636314
- The vasoactive peptide angiotensin-(1-7), its receptor Mas and the angiotensin-converting enzyme type 2 are expressed in the human endometrium. PMID: 19164480
- the Mas oncogene acts as a receptor for Angiotensin (1-7)--REVIEW PMID: 19461648
顯示更多
收起更多
-
相關疾病:The MAS oncogene has a weak focus-inducing activity in transfected NIH 3T3 cells.
-
亞細胞定位:Cell membrane; Multi-pass membrane protein.
-
蛋白家族:G-protein coupled receptor 1 family
-
數據庫鏈接:
Most popular with customers
-
-
YWHAB Recombinant Monoclonal Antibody
Applications: ELISA, WB, IHC, IF, FC
Species Reactivity: Human, Mouse, Rat
-
-
-
-
-
-